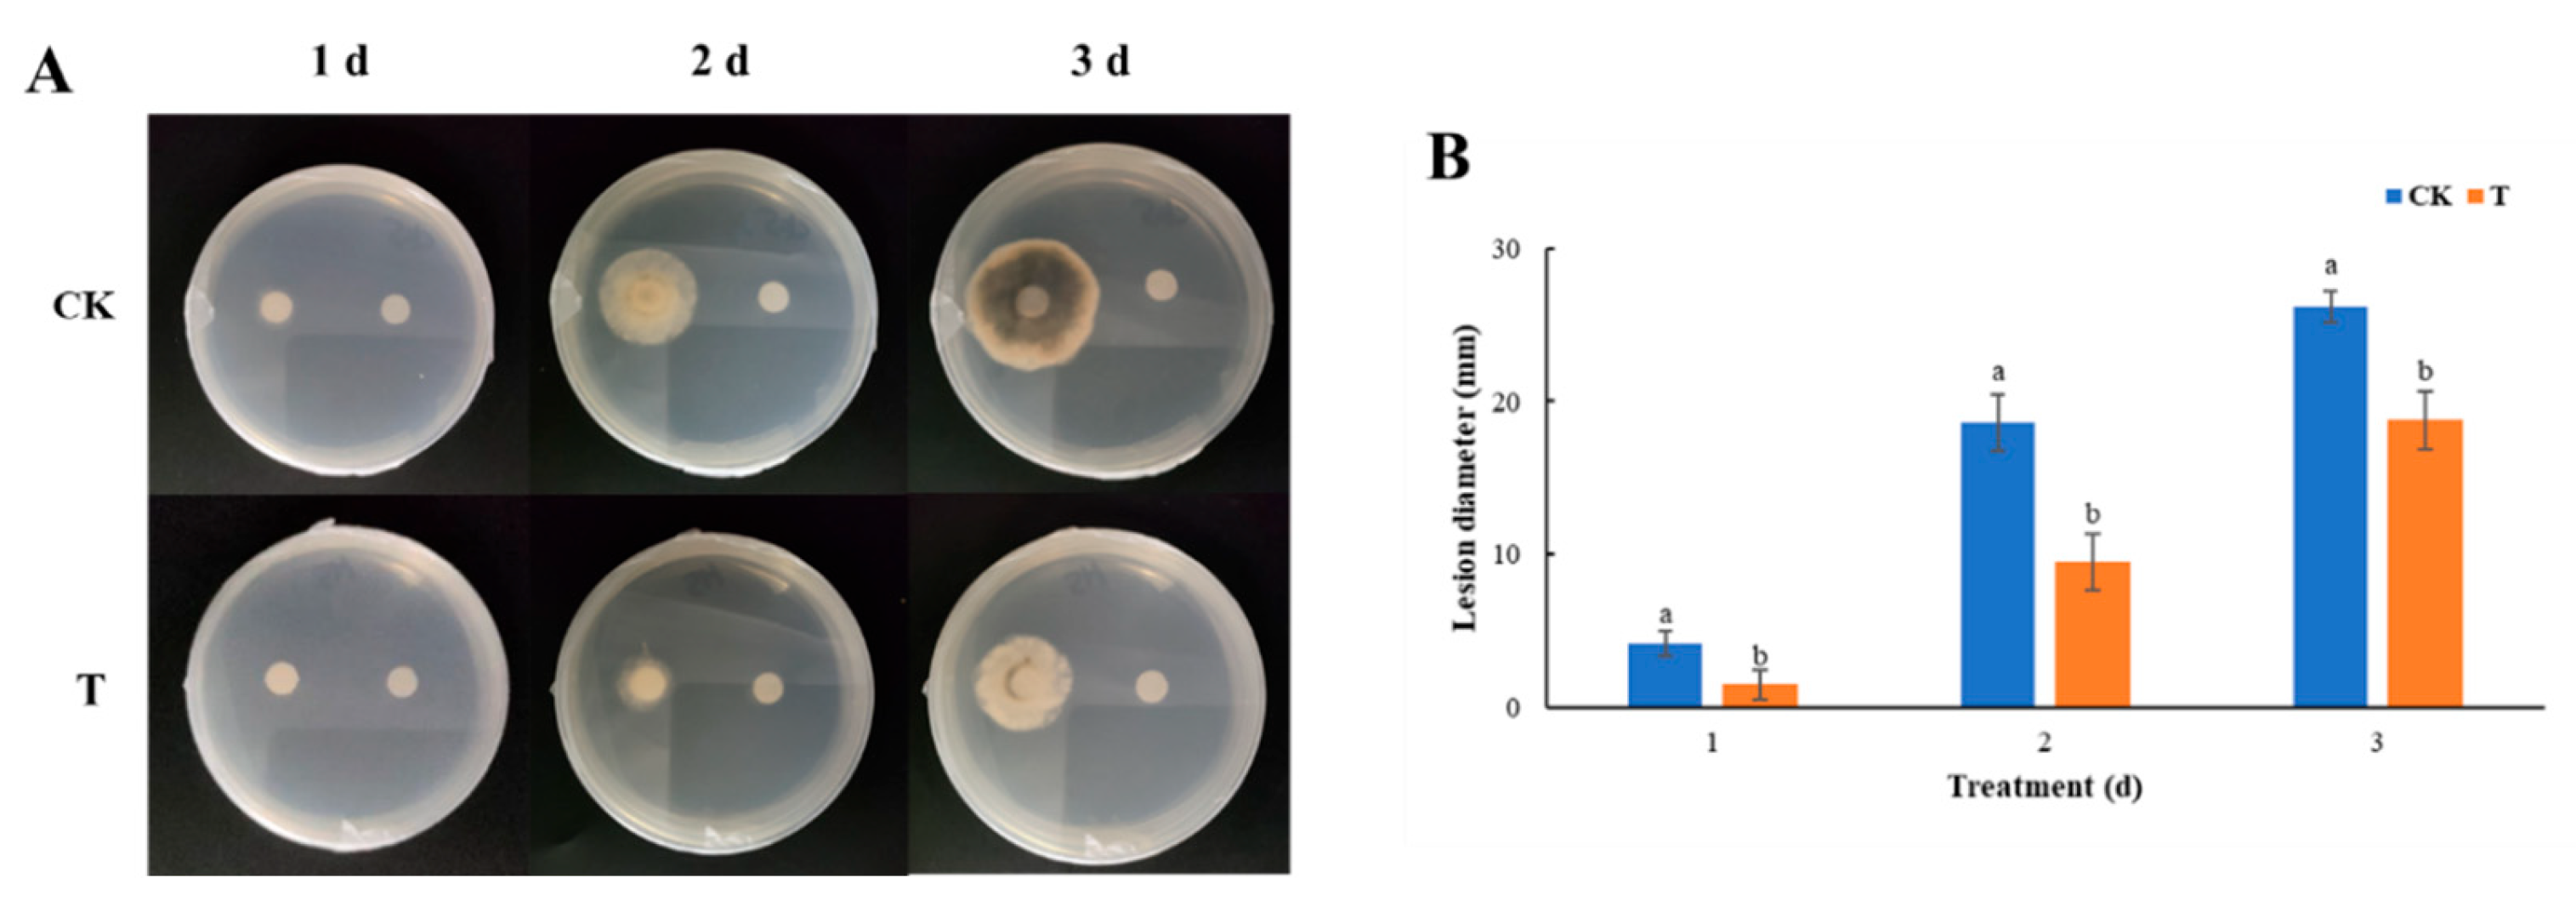
Foods 13 01949 g005

Volatile Organic Compounds of Wickerhamomyces anomalus Prevent Postharvest Black Spot Disease in Tomato
Abstract
1. Introduction
2. Materials and Methods
2.1. Yeast and Pathogen
2.2. Assessing of Nonvolatile Metabolites of W. anomalus on A. alternata
2.3. Impact of Volatile Metabolites of W. anomalus on the Growth of A. alternata
2.4. Effect of W. anomalus Volatile Substances on Tomato Black Spot Disease
2.5. GC-MS Analysis of W. anomalus VOCs
2.6. Effect of Isoamyl Acetate Fumigation on A. alternata In Vitro
2.7. Influence of Isoamyl Acetate Fumigation on Tomato Postharvest Black Spot Disease
2.8. Statistical Analysis
3. Results
3.1. Effect of Nonvolatile Metabolites of W. anomaluson A. alternata
3.2. Effect of Volatile Metabolites of W. anomalus on the Growth of A. alternata
3.3. Effect of Volatile Substances from W. anomalus on Tomato Black Spot Disease
3.4. W. anomalus VOCs Component Analysis (GC-MS)
3.5. Impact of Isoamyl Acetate Fumigation on A. alternata In Vitro
3.6. Effect of Fumigation with Isoamyl Acetate on Control of Postharvest Black Spot of Tomato
4. Discussion
5. Conclusions
Supplementary Materials
Author Contributions
Funding
Institutional Review Board Statement
Informed Consent Statement
Data Availability Statement
Conflicts of Interest
References
- Zhang, X.Y.; Zhou, H.Y.; Han, Z.Y.; Huang, W.Y.; Gu, X.Y.; Li, B.; Zhao, L.A.; Zhou, S.Q.; Zhang, H.Y. Pichia caribbica combined with oligochitosan controlling black spot of tomatoes and the regulation on ROS metabolism of the fruits. Biol. Control 2022, 176, 105109. [Google Scholar] [CrossRef]
- Zhang, X.K.; Li, B.Q.; Zhang, Z.Q.; Chen, Y.; Tian, S.P. Antagonistic yeasts: A promising alternative to chemical fungicides for controlling postharvest decay of fruit. J. Fungi 2020, 6, 158. [Google Scholar] [CrossRef] [PubMed]
- Lahlali, R.; Ezrari, S.; Radouane, N.; Kenfaoui, J.; Esmaeel, Q.; El Hamss, H.; Belabess, Z.; Barka, E.A. Biological control of plant pathogens: A global perspective. Microorganisms 2022, 10, 596. [Google Scholar] [CrossRef] [PubMed]
- Dukare, A.S.; Paul, S.; Nambi, V.E.; Gupta, R.K.; Singh, R.; Sharma, K.; Vishwakarma, R.K. Exploitation of microbial antagonists for the control of postharvest diseases of fruits: A review. Crit. Rev. Food Sci. Nutr. 2019, 59, 1498–1513. [Google Scholar] [CrossRef] [PubMed]
- Shang, L.L.; Bai, X.X.; Chen, C.; Liu, L.J.; Li, M.Y.; Xia, X.S.; Wang, Y. Isolation and identification of a Bacillus megaterium strain with ochratoxin a removal ability and antifungal activity. Food Control 2019, 106, 106743. [Google Scholar] [CrossRef]
- Hashem, M.; Alamri, S.A.; Hesham, A.L.; Al-Qahtani, F.M.H.; Kilany, M. Biocontrol of apple blue mould by new yeast strains: Cryptococcus albidus KKUY0017 and Wickerhamomyces anomalus KKUY0051 and their mode of action. Biocontrol Sci. Technol. 2014, 24, 1137–1152. [Google Scholar] [CrossRef]
- Oufensou, S.; Ul Hassan, Z.; Balmas, V.; Jaoua, S.; Migheli, Q. Perfume guns: Potential of yeast volatile organic compounds in the biological control of mycotoxin-producing fungi. Toxins 2023, 15, 45. [Google Scholar] [CrossRef] [PubMed]
- Huang, X.Q.; Ren, J.; Li, P.H.; Feng, S.; Dong, P.; Ren, M.Z. Potential of microbial endophytes to enhance the resistance to postharvest diseases of fruit and vegetables. J. Sci. Food Agric. 2021, 101, 1744–1757. [Google Scholar] [CrossRef] [PubMed]
- Toffano, L.; Fialho, M.B.; Pascholati, S.F. Potential of fumigation of orange fruits with volatile organic compounds produced by Saccharomyces cerevisiae to control citrus black spot disease at postharvest. Biol. Control 2017, 108, 77–82. [Google Scholar] [CrossRef]
- Liszkowska, W.; Berlowska, J. Yeast fermentation at low temperatures: Adaptation to changing environmental conditions and formation of volatile compounds. Molecules 2021, 26, 1035. [Google Scholar] [CrossRef]
- Razo-Belman, R.; Ozuna, C. Volatile Organic Compounds: A review of their current applications as pest biocontrol and disease management. Horticulturae 2023, 9, 441. [Google Scholar] [CrossRef]
- Chen, O.; Yi, L.H.; Deng, L.L.; Ruan, C.Q.; Zeng, K.F. Screening antagonistic yeasts against citrus green mold and the possible biocontrol mechanisms of Pichia galeiformis (BAF03). J. Sci. Food Agric. 2020, 100, 3812–3821. [Google Scholar] [CrossRef] [PubMed]
- Zhao, X.X.; Zhou, J.Y.; Tian, R.F.; Liu, Y.L. Microbial volatile organic compounds: Antifungal mechanisms, applications, and challenges. Front. Microbiol. 2022, 13, 922450. [Google Scholar] [CrossRef]
- Contarino, R.; Brighina, S.; Fallico, B.; Cirvilleri, G.; Parafati, L.; Restuccia, C. Volatile organic compounds (VOCs) produced by biocontrol yeasts. Food Microbiol. 2019, 82, 70–74. [Google Scholar] [CrossRef] [PubMed]
- Zhu, M.R.; Yang, Q.Y.; Godana, E.A.; Huo, Y.N.; Hu, S.Y.; Zhang, H.Y. Efficacy of Wickerhamomyces anomalus in the biocontrol of black spot decay in tomatoes and investigation of the mechanisms involved. Biol. Control 2023, 186, 105356. [Google Scholar] [CrossRef]
- Shi, Y.; Zhao, Q.H.; Xin, Y.; Yang, Q.Y.; Dhanasekaran, S.; Zhang, X.Y.; Zhang, H.Y. Aureobasidium pullulans S2 controls tomato gray mold and produces volatile organic compounds and biofilms. Postharvest Biol. Technol. 2023, 204, 112450. [Google Scholar] [CrossRef]
- Xi, Y.; Guo, H.; Jiang, Y.; Zhou, J.; Yu, W.; Liu, J.; Xiao, H. Effect of fumigation with volatile metabolites of Hanseniaspora uvarum on aroma components and storage quality of strawberry fruit. Food Sci. 2020, 41, 168–174. [Google Scholar] [CrossRef]
- Arrarte, E.; Garmendia, G.; Rossini, C.; Wisniewski, M.; Vero, S. Volatile organic compounds produced by Antarctic strains of Candida sake play a role in the control of postharvest pathogens of apples. Biol. Control 2017, 109, 14–20. [Google Scholar] [CrossRef]
- Mewa-Ngongang, M.; du Plessis, H.W.; Ntwampe, S.K.O.; Chidi, B.S.; Hutchinson, U.F.; Mekuto, L.; Jolly, N.P. The use of Candida pyralidae and Pichia kluyveri to control spoilage microorganisms of raw fruits used for beverage production. Foods 2019, 8, 454. [Google Scholar] [CrossRef]
- Gonzalez, M.; Celis, A.M.; Guevara-Suarez, M.I.; Molina, J.; Carazzone, C. Yeast smell like what they eat: Analysis of volatile organic compounds of Malassezia furfur in growth media supplemented with different lipids. Molecules 2019, 24, 419. [Google Scholar] [CrossRef]
- Bi, Y.L.; Zhang, X.; Chang, X.F.; Li, J.X.; Xiao, S.; Zhang, B.; Dang, C.; Sun, L.L.; Yao, H.W.; Fang, Q.; et al. Olfactory behavioral responses of two Drosophila species and their pupal parasitoid to volatiles from bananas. Pest Manag. Sci. 2023, 79, 4309–4318. [Google Scholar] [CrossRef] [PubMed]
- Yu, H.; Jiang, B.; Sun, C.; Chen, D.; Wang, Z.; Zhang, Y.; Guo, F.; Zhang, C. Analysis of nectarine odor fingerprints based on headspace-gas chromatography-ion mobility spectroscopy. Food Ferment. Ind. 2020, 46, 231–235. [Google Scholar]
- Buzzini, P.; Martini, A.; Cappelli, F.; Pagnoni, U.M.; Davoli, P. A study on volatile organic compounds (VOCs) produced by tropical ascomycetous yeasts. Antonie Van Leeuwenhoek 2003, 84, 301–311. [Google Scholar] [CrossRef] [PubMed]
- Xie, S.S.; Liu, J.; Gu, S.Y.; Chen, X.J.; Jiang, H.Y.; Ding, T. Antifungal activity of volatile compounds produced by endophytic Bacillus subtilis DZSY21 against Curvularia lunata. Ann. Microbiol. 2020, 70, 2. [Google Scholar] [CrossRef]
- Xing, S.J.; Gao, Y.T.; Li, X.; Ren, H.; Gao, Y.; Yang, H.; Liu, Y.M.; He, S.Q.; Huang, Q. Antifungal activity of volatile components from ceratocystis fimbriata and its potential biocontrol mechanism on Alternaria alternata in postharvest cherry tomato fruit. Microbiol. Spectr. 2023, 11, e02713-22. [Google Scholar] [CrossRef]

| Volatile Compounds | CAS | Chemical Formula | Relative Peak Area Ratio (%) | Odour |
|---|---|---|---|---|
| 1-Butanol, 3-methyl-, acetate | 123-92-2 | C7H14O2 | 40.42 | The smell of bananas |
| 1-Butanol, 2-methyl-, acetate | 624-41-9 | C7H14O2 | 15.61 | The smell of bananas |
| Phenylethyl Alcohol | 60-12-8 | C8H10O | 15.06 | A sweet rose-like fragrance |
| Acetic acid, butyl ester | 123-86-4 | C6H12O2 | 5.17 | - |
| Hexanoic acid, ethyl ester | 123-66-0 | C8H16O2 | 3.04 | Pineapple fruit aroma |
| 3-(Methylthio)propyl acetate | 16630-55-0 | C6H12O2S | 2.96 | - |
| 2,2,4-Trimethyl-1,3-pentanediol diisobutyrate | 6846-50-0 | C16H30O4 | 2.29 | - |
| Acetic acid, 2-phenylethyl ester | 103-45-7 | C10H12O2 | 2.19 | A honey-like aroma with a pink aroma, similar to an apple-like fruit aroma, and with a cocoa and whiskey-like aroma. |
| 1-Propanol, 3-(methylthio)- | 505-10-2 | C4H10OS | 2.05 | Strong smell of onion and meat. |
| Acetic acid, hexyl ester | 142-92-7 | C8H16O2 | 1.57 | Rich fruity smell |
| 1-Hexanol | 111-27-3 | C6H14O | 1.42 | Light green twigs and leaves smell, with wine, fruit, and fat smell |
| 1,2-Benzenedicarboxylic acid, bis(2-methylpropyl) ester | 84-69-5 | C16H22O4 | 1.27 | A slightly aromatic scent |
Disclaimer/Publisher’s Note: The statements, opinions and data contained in all publications are solely those of the individual author(s) and contributor(s) and not of MDPI and/or the editor(s). MDPI and/or the editor(s) disclaim responsibility for any injury to people or property resulting from any ideas, methods, instructions or products referred to in the content. |
© 2024 by the authors. Licensee MDPI, Basel, Switzerland. This article is an open access article distributed under the terms and conditions of the Creative Commons Attribution (CC BY) license (https://creativecommons.org/licenses/by/4.0/).
Share and Cite
Zhang, X.; Yang, Q.; Solairaj, D.; Sallam, N.M.A.; Zhu, M.; You, S.; Zhang, H. Volatile Organic Compounds of Wickerhamomyces anomalus Prevent Postharvest Black Spot Disease in Tomato. Foods 2024, 13, 1949. https://doi.org/10.3390/foods13121949
Zhang X, Yang Q, Solairaj D, Sallam NMA, Zhu M, You S, Zhang H. Volatile Organic Compounds of Wickerhamomyces anomalus Prevent Postharvest Black Spot Disease in Tomato. Foods. 2024; 13(12):1949. https://doi.org/10.3390/foods13121949
Chicago/Turabian StyleZhang, Xi, Qiya Yang, Dhanasekaran Solairaj, Nashwa M. A. Sallam, Marui Zhu, Shengyu You, and Hongyin Zhang. 2024. "Volatile Organic Compounds of Wickerhamomyces anomalus Prevent Postharvest Black Spot Disease in Tomato" Foods 13, no. 12: 1949. https://doi.org/10.3390/foods13121949
APA StyleZhang, X., Yang, Q., Solairaj, D., Sallam, N. M. A., Zhu, M., You, S., & Zhang, H. (2024). Volatile Organic Compounds of Wickerhamomyces anomalus Prevent Postharvest Black Spot Disease in Tomato. Foods, 13(12), 1949. https://doi.org/10.3390/foods13121949

